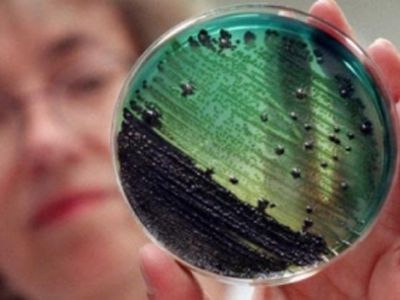
Осторожно: Пищевые заразные заболевания                                                                                                                - В Висагинасе

Стипендия к 450-летию Вильнюсского университета
Это специальная стипендия, учреждённая Вильнюсским университетом для будущих студентов, испытывающих финансовые трудности
Загрузка...
--

Сегодня, 29 февраля, состоялась церемония чествования первого появившегося на свет в этом году жителя Висагинаса

Поток российских туристов в Литву за последние годы значительно увеличился

В художественной галерее Висагинской городской библиотеки 6-20 марта вы погрузитесь в волшебный мир декупажа, вязания спицами и крючком, вышивки крестиком, ...

О церемонии чествовании первого появившегося на свет в этом году жителя Висагинаса смотрите в нашем сюжете сегодня, 29 февраля, как ...

В столице Литвы Вильнюсе работает международная энергетическая конференция, посвященная проблематике разведки, добычи и использования сланцевого газа

Многие годы секретность и анонимность миллионов банковских счетов в Швейцарии считалась наиболее привлекательным фактом для иностранных вкладчиков

Вчера Елена Соловей отпраздновала 65-летний юбилей

В Литве началом старости считается возраст в 65,3 года, тогда как человека перестают считать «молодым» в 47 лет, выяснилось из ...

Японская компания Hitachi, кандидат на строительство Висагинской атомной электростанции, учредила представительство в Вильнюсе, которое будет исследовать возможности инвестиций других компаний ...

Американская компания услуг геополитического и стратегического анализа Strategic Forecasting, Inc

Страны-члены Европейского союза достигли договоренности об отзыве своих послов из Белоруссии в качестве ответа на отзыв Минском постоянного представителя при ...

В Латвии смогут исключать учащихся средних школ за неоднократное проявление неуважения к государству и его основным ценностям

Premjeras teigia, kad pokalbiai su „Gazprom“ tampa konstruktyvesni, ir tikisi, jog daugiau geranoriškumo bus ir derantis dėl dujų kainų




Возвращение земли законным владельцам длится в Литве вот уже 20 лет

По наблюдениям инструкторов Школы Безопасного Вождения в Латвии (DBS), больше всего волнений представительницам прекрасного пола доставляет парковка

Вчера Еврокомиссия в последний раз предупредила восемь стран Евросоюза, которые до сих пор не внесли изменения в национальное законодательство в ...

Из сводки криминальных происшествий


В воскресенье экс-премьер Литвы Казимира Прунскене была госпитализирована в Сантаришкскую клинику, где у нее диагностировали инсульт

Министерство охраны края Литвы сообщило, что в 2011 году только на войну в Афганистане Литва израсходовала около 54 млн


Президент Латвии Андрис Берзиньш выступил в поддержку ветеранов латышского легиона SS, сообщает Mixnews

Состоятельные люди гораздо чаще совершают неэтичные поступки, чем бедные, сумели доказать ученые из США и Канады
О заболеваниях, которые могут передаваться от животного к человеку, напоминает Висагинское отделение государственной ветеринарно-пищевой службы

Ученые Калифорнийского университета в Беркли нашли способ улучшить зрение людей, страдающих старческой дальнозоркостью, без очков

С 1 марта 2012 года в Литве вступают в силу новые стандарты к выбросам выхлопных газов из дизельных двигателей легковых ...

Министры иностранных дел стран-участниц Евросоюза в понедельник, 27 февраля, договорились о предоставлении Сербии статуса кандидата на вступление в организацию